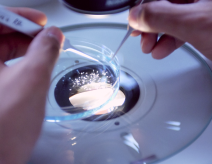

Licenses
All graphical assets in this template are licensed for personal and commercial use. If you'd like to use a specific asset, please check the license below
Images
Unsplash
All images and profile pictures below are from Unsplash.com
Other Graphics
Other design elements and illustrations created by EGO Creative Innovations Limited. And subject of this license.
bewertungen & Zertifikate
leistungsschwerpunkte
Kontakt
St.Ingberter Str. 65,
66123 Saarbrücken (Rotenbühl)